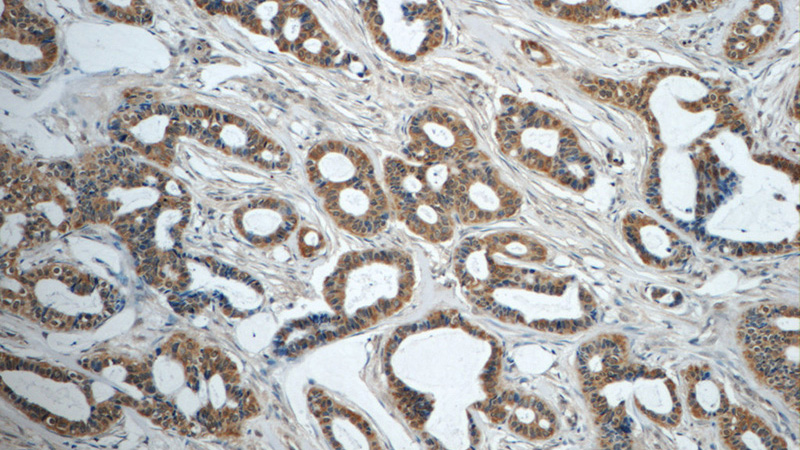
Immunohistochemistry of paraffin-embedded human breast cancer tissue slide using Catalog No:107629(TNF-a Antibody) at dilution of 1:50 (under 10x lens)

-
Product Name
TNF alpha antibody
- Documents
-
Description
TNF alpha Mouse Monoclonal antibody. Positive IHC detected in human breast cancer tissue, human colon cancer tissue, human liver cancer tissue. Positive WB detected in LPS treated RAW 264.7 cells. Observed molecular weight by Western-blot: 17 kDa
-
Tested applications
ELISA, IHC, WB
-
Species reactivity
Human, Mouse; other species not tested.
-
Alternative names
Cachectin antibody; DIF antibody; TNF antibody; TNF a antibody; TNF alpha antibody; TNFA antibody; TNF-a antibody; TNFSF2 antibody; Tumor necrosis factor antibody
-
Isotype
Mouse IgG2b
-
Preparation
This antibody was obtained by immunization of TNF alpha recombinant protein (Accession Number: NM_000594). Purification method: Protein A purified.
-
Clonality
Monoclonal
-
Formulation
PBS with 0.02% sodium azide and 50% glycerol pH 7.3.
-
Storage instructions
Store at -20℃. DO NOT ALIQUOT
-
Applications
Recommended Dilution:
WB: 1:500-1:5000
IHC: 1:20-1:200
-
Validations

LPS treated RAW 264.7 cells were subjected to SDS PAGE followed by western blot with Catalog No:107629(TNF-a Antibody) at dilution of 1:1000
Immunohistochemistry of paraffin-embedded human breast cancer tissue slide using Catalog No:107629(TNF-a Antibody) at dilution of 1:50 (under 10x lens)

Immunohistochemistry of paraffin-embedded human breast cancer tissue slide using Catalog No:107629(TNF-a Antibody) at dilution of 1:50 (under 40x lens)
-
Background
TNF, as also known as TNF-alpha, or cachectin, is a multifunctional proinflammatory cytokine that belongs to the tumor necrosis factor (TNF) superfamily. It is expressed as a 26 kDa membrane bound protein and is then cleaved by TNF-alpha converting enzyme (TACE) to release the soluble 17 kDa monomer, which forms homotrimers in circulation. It is produced chiefly by activated macrophages, although it can be produced by many other cell types such as CD4+ lymphocytes, NK cells, neutrophils, mast cells, eosinophils, and neurons. It can bind to, and thus functions through its receptors TNFRSF1A/TNFR1 and TNFRSF1B/TNFBR. This cytokine is involved in the regulation of a wide spectrum of biological processes including cell proliferation, differentiation, apoptosis, lipid metabolism, and coagulation. This cytokine has been implicated in a variety of diseases, including autoimmune diseases, insulin resistance, and cancer.
-
References
- Wu Y, Huang A, Li T. MiR-152 reduces human umbilical vein endothelial cell proliferation and migration by targeting ADAM17. FEBS letters. 588(12):2063-9. 2014.
- Xia X, Su C, Fu J. Role of α-lipoic acid in LPS/d-GalN induced fulminant hepatic failure in mice: studies on oxidative stress, inflammation and apoptosis. International immunopharmacology. 22(2):293-302. 2014.
- Xu D, Hu L, Su C. Tetrachloro-p-benzoquinone induces hepatic oxidative damage and inflammatory response, but not apoptosis in mouse: the prevention of curcumin. Toxicology and applied pharmacology. 280(2):305-13. 2014.
- Wang D, Chen S, Liu M, Liu C. Maternal obesity disrupts circadian rhythms of clock and metabolic genes in the offspring heart and liver. Chronobiology international. 32(5):615-26. 2015.
- Zhai Y, Wu B, Li J, Yao XY, Zhu P, Chen ZN. CD147 promotes IKK/IκB/NF-κB pathway to resist TNF-induced apoptosis in rheumatoid arthritis synovial fibroblasts. Journal of molecular medicine (Berlin, Germany). 94(1):71-82. 2016.
- Wang C, Li H, Luo C. The effect of maternal obesity on the expression and functionality of placental P-glycoprotein: Implications in the individualized transplacental digoxin treatment for fetal heart failure. Placenta. 36(10):1138-47. 2015.
- Shi Q, Song X, Fu J. Artificial sweetener neohesperidin dihydrochalcone showed antioxidative, anti-inflammatory and anti-apoptosis effects against paraquat-induced liver injury in mice. International immunopharmacology. 29(2):722-9. 2015.
- Lei X, Cui K, Liu Q. Exogenous Estradiol Benzoate Induces Spermatogenesis Disorder through Influencing Apoptosis and Oestrogen Receptor Signalling Pathway. Reproduction in domestic animals = Zuchthygiene. 51(1):75-84. 2016.
Related Products / Services
Please note: All products are "FOR RESEARCH USE ONLY AND ARE NOT INTENDED FOR DIAGNOSTIC OR THERAPEUTIC USE"
